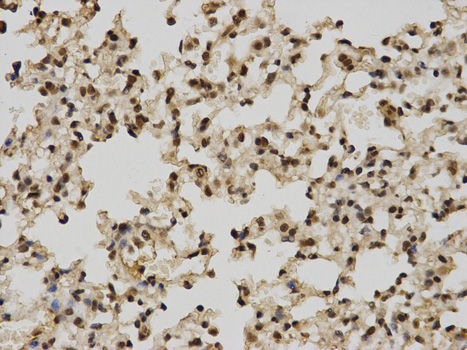
Product Image

Anti-POLR2C Antibody
A30494
ApplicationsWestern Blot, ImmunoHistoChemistry
Product group Antibodies
ReactivityHuman, Mouse, Rat
Overview
- SupplierAntibodies.com
- Product NameAnti-POLR2C Antibody
- Delivery Days Customer7
- ApplicationsWestern Blot, ImmunoHistoChemistry
- CertificationResearch Use Only
- ClonalityPolyclonal
- ConjugateUnconjugated
- Estimated Purity>95%
- HostRabbit
- Scientific DescriptionRabbit polyclonal antibody to POLR2C
- ReactivityHuman, Mouse, Rat
- UNSPSC12352203

![POLR2C antibody [N1C3-2] detects POLR2C protein at nucleus on mouse liver by immunohistochemical analysis. Sample: Paraffin-embedded mouse liver. POLR2C antibody [N1C3-2] (GTX118715) dilution: 1:500.
Antigen Retrieval: Trilogy? (EDTA based, pH 8.0) buffer, 15min](https://www.genetex.com/upload/website/prouct_img/normal/GTX118715/GTX118715_41388_IHC_M_w_23060519_728.webp)